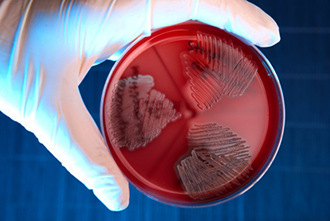

Провоцирующие факторы
Ангина — это инфекционное заболевание, вызванное бактериальными микроорганизмами, такими как стрептококки и стафилококки. Основными источниками инфекции являются больные люди и носители бактерий, а также продукты питания и предметы быта, загрязненные этими патогенами. У детей особенно опасны игрушки и общие вещи, так как инфекция может передаваться не только через воздух, но и через пищу. Остатки инфицированной слюны на таких предметах при недостаточной гигиене могут способствовать проникновению стрептококков и стафилококков в организм, воздействуя на миндалины.
Однако контакт с больным или инфицированным человеком не всегда приводит к заболеванию у детей. Частые случаи ангины могут быть связаны с другими факторами. Чтобы возбудитель, попавший на миндалины, вызвал инфекционный процесс, необходимы определенные предрасполагающие условия.
Частая ангина у ребенка может быть вызвана следующими факторами:
- ослабленным иммунитетом;
- сопутствующими заболеваниями в области носоглотки;
- хроническими инфекциями в организме;
- психогенными факторами;
- неблагоприятной экологической ситуацией.
Частые случаи ангины у детей вызывают беспокойство у родителей и требуют внимания специалистов. Врачи отмечают, что основными факторами, способствующими развитию этого заболевания, являются ослабленный иммунитет и частые вирусные инфекции. Дети, особенно в возрасте до 5 лет, подвержены простудам и гриппу, что может привести к воспалению горла. Кроме того, врачи указывают на важность условий, в которых растет ребенок: недостаточная вентиляция помещений, переохлаждение и плохое питание могут усугубить ситуацию. Также стоит учитывать, что дети часто контактируют друг с другом в детских садах и школах, что увеличивает риск передачи инфекций. Важно следить за состоянием здоровья ребенка, укреплять его иммунитет и своевременно обращаться к врачу при первых признаках болезни.

Снижение иммунитета
Среди факторов, способствующих снижению иммунной защиты у детей, выделяются недостаточное питание, переутомление и несоблюдение режима дня. Ключевым аспектом формирования крепкого иммунитета является грудное вскармливание. Оно обеспечивает малыша всеми необходимыми питательными веществами, что играет важную роль в развитии иммунной системы. Дети, находившиеся на грудном вскармливании, имеют более высокие шансы на формирование сильного иммунитета.
Недоношенные дети чаще подвержены инфекционным заболеваниям, так как из-за недостатка веса они не получают достаточное количество витаминов и микроэлементов, а развитие их органов и систем происходит с задержкой. Это также касается детей, получивших травмы при родах или имеющих врожденные патологии.
Дети с астеническим телосложением чаще страдают от инфекций. Наследственность также играет значительную роль в развитии ангины у детей. При сборе анамнеза ЛОР-врач или педиатр часто обнаруживают, что у родителей также была эта патология.
У детей многие защитные механизмы находятся на стадии формирования. Поэтому для предотвращения инфекционных заболеваний крайне важно обеспечить надлежащий уход и проводить общеукрепляющие мероприятия, такие как:
- соблюдение режима сна и отдыха;
- полноценное и сбалансированное питание, содержащее все необходимые витамины и белки как животного, так и растительного происхождения;
- регулярные прогулки на свежем воздухе;
- соответствие одежды погодным условиям;
- физическая активность, включая гимнастику;
- создание положительных эмоций.
Игнорирование этих условий может привести к сбоям в работе различных систем организма и снижению защитных функций. В результате организм становится более уязвимым к патогенным микроорганизмам.
Недостаток сна, отсутствие в рационе полезных веществ или местное переохлаждение могут ослабить защитные реакции организма.
Закаливание рекомендуется проводить постепенно и под контролем педиатра, учитывая состояние здоровья ребенка, его индивидуальные особенности и наличие сопутствующих заболеваний. Пренебрежение советами специалистов может усугубить ситуацию и привести к переохлаждению.
Перенесенные респираторные заболевания, такие как грипп и другие ОРВИ, значительно снижают иммунитет. В этот период организм становится особенно уязвимым к воздействию дополнительных инфекционных агентов, включая те, что вызывают ангину. Снижение заболеваемости респираторными инфекциями также способствует профилактике ангины. В дополнение к общеукрепляющим мероприятиям важной мерой профилактики ОРВИ является соблюдение гигиенических норм, поддержание чистоты в помещениях и регулярное проветривание.
| Причина частых ангин | Описание | Что делать? |
|---|---|---|
| Сниженный иммунитет | Незрелая иммунная система, недостаток витаминов и микроэлементов, хронические заболевания. | Здоровое питание, богатое витаминами и минералами, закаливание, профилактика хронических заболеваний, консультация иммунолога. |
| Наследственная предрасположенность | Генетическая склонность к частым инфекционным заболеваниям. | Регулярные профилактические осмотры, своевременное лечение инфекций, укрепление иммунитета. |
| Неблагоприятные условия окружающей среды | Загрязненный воздух, курение в помещении, контакт с больными людьми. | Прогулки на свежем воздухе, избегание контакта с больными, отказ от курения в доме. |
| Нарушение микрофлоры носоглотки | Дисбактериоз, снижение количества полезных бактерий. | Пробиотики, санация носоглотки (по назначению врача). |
| Анатомические особенности строения миндалин | Увеличенные аденоиды, крипты миндалин, затрудняющие отток секрета. | Консультация ЛОР-врача, возможно хирургическое вмешательство (аденоидэктомия, тонзиллэктомия). |
| Недостаток гигиены | Редкое мытье рук, использование общих предметов гигиены. | Обучение ребенка правилам гигиены, регулярное мытье рук. |
| Частые стрессовые ситуации | Психоэмоциональное напряжение ослабляет иммунитет. | Создание комфортной психологической атмосферы, помощь в преодолении стресса. |
Сопутствующая патология
Причина, по которой дети часто страдают от ангины, может быть связана с сопутствующими заболеваниями, такими как гайморит или отит. Эти заболевания вызываются определёнными микроорганизмами, создающими инфекционный очаг в организме. В результате иммунная система вынуждена работать с повышенной нагрузкой, чтобы справиться с бактериями. Это ослабляет защитные функции организма и способствует развитию ангины. Ситуацию усугубляет применение антибиотиков, назначаемых для лечения воспалительных процессов.
Некорректное или неоправданное использование антибиотиков может значительно ослабить иммунитет пациента. Назначение таких препаратов негативно сказывается на компенсаторных механизмах организма. Неправильная дозировка и продолжительность лечения могут привести к возникновению устойчивых к антибиотикам микроорганизмов, что увеличивает вероятность присоединения стрептококка или стафилококка.
Развитию воспалительных процессов в носоглотке, синуситах и отитах также способствуют увеличенные аденоиды, что особенно характерно для детей. Их разрастание сужает просвет слуховой трубы, что может привести к отиту среднего уха или гаймориту. Поэтому, исследуя причины частых ангин у детей, отоларинголог обязательно обращает внимание на состояние аденоидов.
Аденоидит является одним из факторов, способствующих образованию постоянного очага инфекции в организме. В некоторых случаях удаление аденоидов приводит к снижению частоты ангин.
Инфекционным очагом, способствующим развитию ангины у детей, может быть и хроническое воспаление в полости рта, например, кариес. Этот хронический инфекционный процесс ослабляет иммунитет, увеличивая риск сопутствующих заболеваний. То же самое касается тяжёлых хронических заболеваний различных органов и систем, таких как сердечно-сосудистая система, желудочно-кишечный тракт, системные патологии, туберкулёз, вирусные гепатиты и другие.
Многие родители сталкиваются с частыми ангинами у своих детей и задаются вопросом, почему это происходит. Одной из основных причин является слабый иммунитет, который может быть вызван недостаточным питанием, стрессом или частыми простудами. Некоторые специалисты отмечают, что дети, посещающие детские сады или школы, чаще подвержены инфекциям из-за близкого контакта с другими детьми. Также стоит учитывать, что ангины могут быть следствием аллергий или хронических заболеваний, таких как аденоиды. Важно следить за гигиеной, укреплять иммунную систему и своевременно обращаться к врачу, чтобы избежать осложнений и снизить частоту заболеваний. Родители должны быть внимательны к симптомам и не игнорировать их, чтобы обеспечить ребенку здоровье и комфорт.

Психоэмоциональный фон
Психогенные факторы играют важную роль в возникновении различных патологий. Негативные эмоции и стресс могут вызывать заболевания нервной и эндокринной систем, кожные болезни, а также способствовать развитию язвенной болезни и других состояний, связанных со снижением защитных механизмов организма. Регулярное наблюдение за детьми с такими заболеваниями выявило связь между развитием патологии и наличием стрессовых ситуаций или тревожности у ребенка.
Пребывание в детском коллективе может стать причиной повышенной заболеваемости из-за близкого контакта детей в ограниченном пространстве, например, в игровой или классной комнате. Также это может быть связано с нежеланием посещать коллектив и отсутствием взаимопонимания среди сверстников или в семье. После исключения сопутствующих заболеваний, инфекционных очагов и генетических факторов пациенту рекомендуется консультация у невропатолога, психолога или психотерапевта. Эти специалисты должны выяснить, какие психоэмоциональные факторы могут провоцировать проблемы. Улучшение обстановки в семье или учебном заведении может значительно снизить частоту случаев ангины у детей.
Неблагоприятный экологический фон
В последние годы вопросы экологии и охраны окружающей среды становятся все более актуальными на различных платформах — от политических до общественных и медицинских. Ухудшение экологической ситуации серьезно влияет на здоровье людей по всему миру, как взрослых, так и детей. Это приводит к сокращению продолжительности жизни и способствует развитию хронических заболеваний, таких как болезни легких, сердечно-сосудистые расстройства, онкологические заболевания и аллергии.
Загрязненный воздух, содержащий пыль и химические вещества, а также выхлопные газы, негативно сказываются на состоянии миндалин, ослабляя их защитные функции и местный иммунитет. В таких условиях инфекционные агенты, такие как стрептококки и стафилококки, могут быстрее вызывать ангину. Детям, страдающим от этой болезни, рекомендуется находиться вдали от промышленных зон и городских территорий. Им полезно дышать свежим воздухом леса или моря.
Источники: medscape.com, health.harvard.edu, medicalnewstoday.com.

Вопрос-ответ
Как часто ребенок может болеть ангиной?
Считается, что ребенок часто болеет ангиной, если она возникает более 4-5 раз в год. Частые случаи заболевания значительно ухудшают качество жизни, повышают риск развития осложнений. Если при однократной ангине ребенка наблюдает и лечит педиатр, то при частых случаях заболевания необходимо наблюдение лор-врача.
Почему у ребенка ангина психосоматика?
Говоря об ангине, психосоматика может также играть не последнюю роль. Так, психологи предполагают, что причиной возникновения ангины у ребенка вполне может быть отсутствие возможности высказывать свое мнение, говорить о том, что ему не нравится. Родители, рекомендуем обратить внимание на данный любопытный факт.
Советы
СОВЕТ №1
Регулярно укрепляйте иммунитет ребенка. Обеспечьте ему сбалансированное питание, богатое витаминами и минералами, а также достаточное количество физической активности на свежем воздухе.
СОВЕТ №2
Следите за гигиеной. Обучите ребенка правилам личной гигиены, таким как регулярное мытье рук, особенно перед едой и после посещения общественных мест, чтобы снизить риск заражения инфекциями.
СОВЕТ №3
Избегайте переохлаждения. Одевайте ребенка по погоде и старайтесь избегать длительного пребывания на холоде, особенно в сырую и ветреную погоду, чтобы предотвратить развитие ангины.
СОВЕТ №4
Регулярно посещайте врача. Проводите профилактические осмотры у педиатра и следите за состоянием здоровья ребенка, чтобы вовремя выявлять и лечить возможные заболевания.